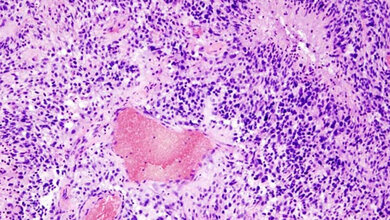
Glioblastom_histologisches_Praeparat_HE_Faerbung_Autor_KGH_CC_BY_SA_3_0.jpg Hirntumoren

Ein Forschungsteam des Instituts für Humangenetik des Universitätsklinikums Schleswig-Holstein (UKSH), der Medizinischen Fakultät der Christian-Albrechts-Universität zu Kiel und der Universität zu Lübeck hat einen Algorithmus entwickelt, der durch maschinelles Lernen vorhersagen kann, ob Genvarianten für bestimmte Krankheiten verantwortlich sein können. So ermöglicht er bessere Diagnosen bei seltenen angeborenen Erkrankungen. Durch die Arbeit mit dem STIGMA (single-cell tissue-specific gene prioritization using machine learning) genannten Algorithmus haben die Forscherinnen und Forscher bereits mehrere neue Krankheitsgene identifiziert.
Vergleich von Genen mit STIGMA
Bei nur ungefähr einem Drittel der über 21.000 menschlichen Gene ist bekannt, welche Funktion sie haben. Darüber hinaus trägt jeder Mensch Varianten in seinem Genom, die zum großen Teil zur normalen persönlichen Variabilität gehören, aber auch Krankheiten verursachen können. Bei einem Verdacht auf eine seltene angeborene Erkrankung werden bei genetischen Analysen immer wieder Varianten gefunden, die nicht einzuordnen sind. Um herauszufinden, ob sie im konkreten Fall eine Rolle spielen, sind in der Regel aufwendige experimentelle Untersuchungen nötig. Der Algorithmus STIGMA vergleicht bekannte Krankheitsgene in der Embryonalentwicklung mit potentiellen neuen Krankheitsgenen. Die Daten zu den bekannten Genen stammen zum Beispiel aus Einzelzellanalysen (single-cell sequencing) wie dem Human Cell Atlas.
Mehrere neue Krankheitsgene identifiziert
„Der Algorithmus kann anhand von Krankheitsgenen erkennen, in welchen Geweben zum Beispiel des Herzens besonders häufig ähnliche Gene exprimiert sind, die dann auch zu einer Erkrankung führen. Er kann prognostizieren, ob ein Gen, in dem wir eine Variante gefunden haben, für eine Krankheit verantwortlich ist oder eher eine Normvariante darstellt, die nichts damit zu tun hat. So bekommt jedes Gen einen Krankheits-Score, den wir STIGMA-Score nennen“, erklärt Saranya Balachandran, Erstautorin und wissenschaftliche Mitarbeiterin des Instituts für Humangenetik. Sie hat zusammen mit Dr. Varuun Sreenivasan, Letztautor und wissenschaftlicher Mitarbeiter des Instituts für Humangenetik, den Algorithmus entwickelt. Durch den neuen Algorithmus konnten bereits mehrere neue Krankheitsgene identifiziert werden, die zu angeborenen Herzfehlern führen. Identifiziert wurde auch ein weiteres Gen, das Fehlbildungen der Hände verursacht. „Bislang verhelfen genetische Analysen bei Patientinnen und Patienten nur in etwa 30 Prozent der Fälle auch zu einer Diagnose. STIGMA kann dieses Ergebnis deutlich verbessern. Gleichzeitig erweitern wir unser Wissen über die Funktion einzelner Gene – ohne weitere aufwendige Experimente, allein durch die Anwendung maschinellen Lernens“, sagt Prof. Dr. Malte Spielmann, Direktor des Instituts für Humangenetik und ebenfalls Letztautor der Veröffentlichung.
Beteiligt an der Arbeit waren Expertinnen und Experten der Klinik für angeborene Herzfehler und Kinderkardiologie des UKSH, Campus Kiel, des Max-Planck-Instituts für Molekulare Genetik in Berlin, des Instituts für Medizinische Genetik und Humangenetik der Charité Universitätsmedizin Berlin, des Instituts für Medizinische Genetik der Universität Oldenburg, des Deutschen Zentrums für Herz-Kreislauf-Forschung und eine Forschungseinrichtung in Pakistan.
Quelle: idw/UKSH
Artikel teilen